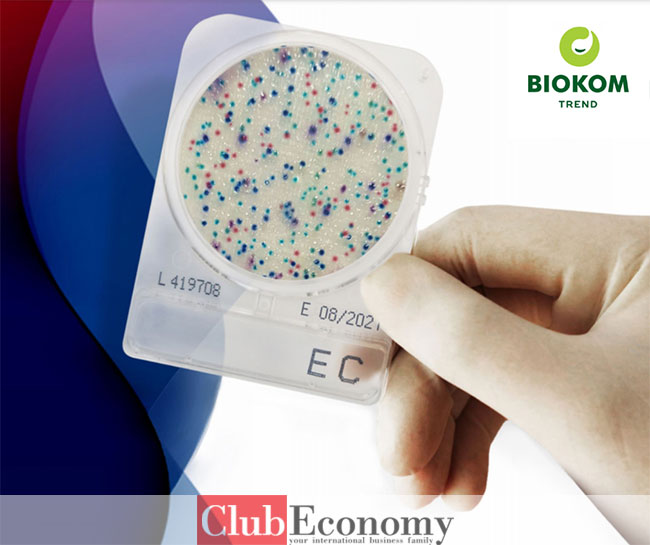

Подетално за компанијата
Компанијата Биоком Тренд ДООЕЛ е дел од Биоком групацијата, присутна на пазарот во Македонија од Јули 2011 година е една од водечките компании во делот на продажбата на производи наменети за прехранбената индустрија, медицина, ветерина, хотели и ресторани. Биоком на ниво на групација е присутна во повеќе земји што овозможува чекор понапред во следењето на светски трендови. Во Биоком работи високо мотивиран и квалификуван кадар, со особено искуство во областа на својата професионална распределба, кои несебично го користат своето знаење во насока на пронаоѓање на соодветните идеални решенија за потребите на клиентите. Сведоци на нашата долгогодишна работа се компании како Битолска млекара, Здравје Битола, Бучен Козјак, Вемилк, Идеал Шипка, Трница, Осогово Милк, Малешево Милк, Витаминка, Брилијант, Макпрогрес, Тиквеш, Визиана, Вивакс, Галафарм,...


Контакт информации
Адреса
Улица: Ул. Методија Шаторов Шарло бр. 26/2-6, 1000 Скопје
Град: Скопје
Држава: Македонија